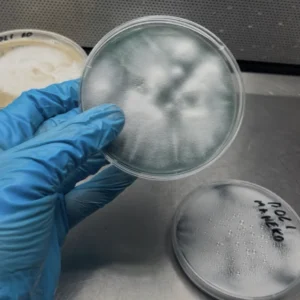
Cepa madre de Ostra Rey Perla Negra en PDA

En Amanita Labs trabajamos para devolver el control de la alimentación a las personas.
Creemos que los hongos son aliados fundamentales para construir sistemas alimentarios locales, resilientes y libres de dependencias externas.
Promovemos el derecho a saber cultivar, a acceder a alimentos frescos y a fortalecer comunidades desde la raíz.
No solo cultivamos hongos, cultivamos conexiones. Cada cultivo y cosecha es una oportunidad para reunirnos, compartir saberes y fortalecer los lazos que nos alimentan el alma tanto como el cuerpo
Te damos las herramientas para que seas el protagonista de tu alimentación. Ver crecer tu propio alimento te cambia: transforma la dependencia en confianza y el consumir en crear.
Tomamos el control de los medios de producción alimentaria. No pedimos permiso para decidir qué comemos, cómo lo producimos y con quién lo compartimos
En Amanita Labs investigamos, cultivamos y transformamos hongos gourmet y medicinales en soluciones biotecnológicas sostenibles. Promovemos la innovación, la salud y la educación micológica desde Chile para toda Latinoamérica.
Desde la biotecnología fúngica, en Amanita Labs impulsamos proyectos que conectan ciencia, naturaleza y comunidad. Cultivamos hongos, saberes y soluciones que regeneran la salud y el entorno.
Amanita Labs © 2025